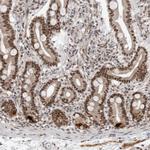
PRDM10 Antibody in Immunohistochemistry (Paraffin) (IHC (P))

Search
Invitrogen
PRDM10 Polyclonal Antibody
{{$productOrderCtrl.translations['antibody.pdp.commerceCard.promotion.promotions']}}
{{$productOrderCtrl.translations['antibody.pdp.commerceCard.promotion.viewpromo']}}
{{$productOrderCtrl.translations['antibody.pdp.commerceCard.promotion.promocode']}}: {{promo.promoCode}} {{promo.promoTitle}} {{promo.promoDescription}}. {{$productOrderCtrl.translations['antibody.pdp.commerceCard.promotion.learnmore']}}
产品信息
PA5-82948
种属反应
宿主/亚型
分类
类型
抗原
偶联物
形式
浓度
规格
纯化类型
保存液
内含物
保存条件
运输条件
RRID
产品详细信息
Immunogen sequence: SPSHIQGSSS TQGQALQQQQ QQQQNSSVQH TYLPSAWNSF RGYSSEIQMM TLPPGQFVIT DSGVATPVTT GQVKAVTSGH YVLSESQSEL EEKQTSALSG GVQVEPPAHS DSLDPQTNSQ QQTTQYIITT TTNGNGS
Highest antigen sequence indentity to the following orthologs: Rat - 88%, Mouse - 88%.
靶标信息
GPIP137 may regulate the transport and translation of mRNAs of proteins involved in synaptic plasticity in neurons and cell proliferation and migration in multiple cell types. It is expressed in the cytoplasm.
仅用于科研。不用于诊断过程。未经明确授权不得转售。
篇参考文献 (0)
生物信息学
蛋白别名: MGC131802; PFM7; PR domain 10; PR domain containing 10; PR domain zinc finger protein 10; PR domain-containing protein 10; PR-domain family member 7; PRDM zinc finger transcription factor; Tristanin; unnamed protein product
基因别名: BHD2; KIAA1231; PFM7; PRDM10; TRIS
UniProt ID: (Human) Q9NQV6
Entrez Gene ID: (Human) 56980